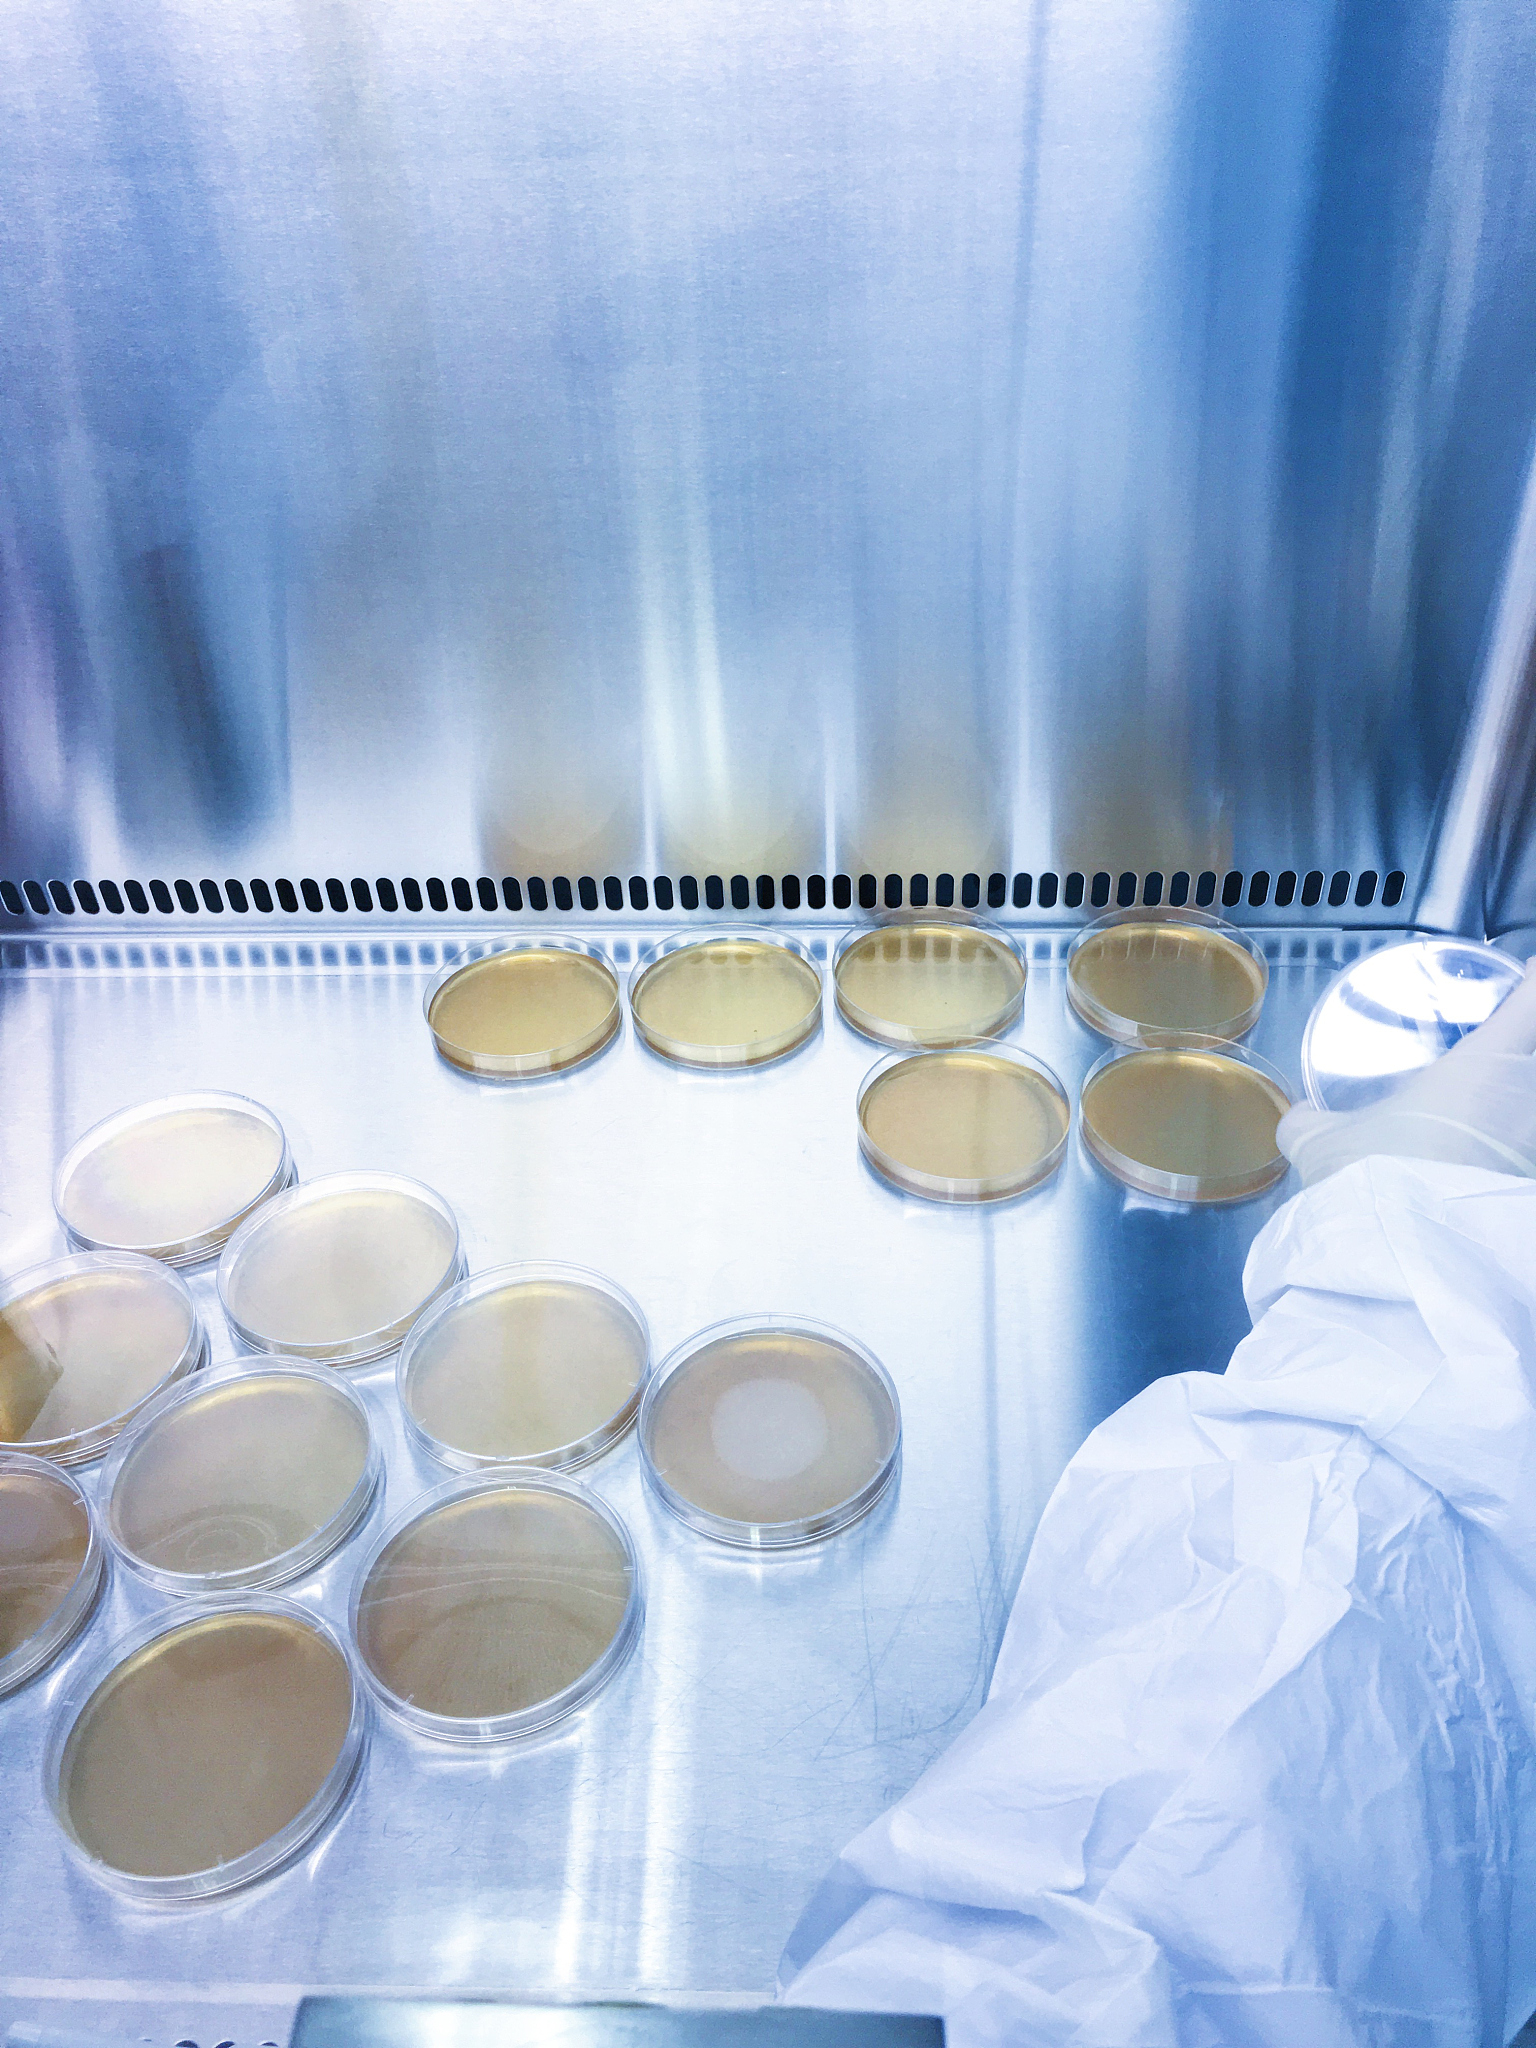
西安医学高等专科学校热门专业推荐：临床医学、护理学、医学影像技术等

西安医学高等专科学校热门专业推荐:临床医学、护理学、医学影像技术等
西安医学高等专科学校是一所以医学为主的高等学府,其拥有众多专业供学生选择。那么,哪些专业是最受欢迎的呢?
首先,该校的医学类专业是最受欢迎的,包括'临床医学'、'口腔医学'、'中医学'等。这些专业不仅是该校的优势专业,也是社会上最需要的专业之一。学生在这些专业中学到的知识和技能可以为社会健康事业做出贡献。
在医学类专业中,不同的方向也有不同的需求量。例如,'临床医学'专业是最受欢迎的医学类专业之一,因为临床医学专业的学生将成为未来的医生,为社会健康事业做出贡献。而在临床医学专业中,不同的科室也有不同的需求量。例如,'心内科'和'呼吸内科'是当前社会上需求量比较大的科室之一,因为这些科室的疾病在社会上的发病率较高。
其次,该校的'护理学'专业也备受青睐。随着人口老龄化的加剧,护理人员的需求量也越来越大。在这个专业中,学生将学到如何照顾患者、如何处理紧急情况等知识和技能,为未来的工作打下坚实的基础。
此外,该校的'医学影像技术'专业和'医学实验技术'专业也是热门专业之一。随着医学技术的不断进步,这些专业的需求量也越来越大。学生在这些专业中将学到如何操作医疗设备、如何进行医学实验等技能,为未来的工作做好准备。
总之,西安医学高等专科学校拥有众多优秀的专业供学生选择,无论选择哪个专业,只要努力学习,就可以在未来的工作中获得成功。
原文地址: https://www.cveoy.top/t/topic/g1Rs 著作权归作者所有。请勿转载和采集!